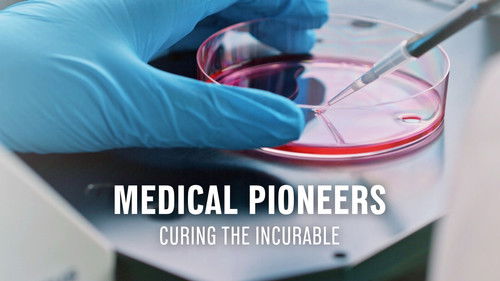
Medical Pioneers - Curing The Incurable

Found 66 movies, 41 TV shows, and 20 people
Can't find what you're looking for?

Ryutaro Asada was the chief surgeon of Team Medical Dragon, a globally active emergency medical care team that worked in refugee camps. After his return to Japan, this amazingly talented surgeon starts work at a university hospital, where he uncovers one case of corruption after another and takes on a lot of powerful contenders in this heroic drama. The struggles between the hospital and the patients, the infighting among the hospital staff, and the patients who get involved in those struggles are all depicted in a realistic manner in a drama that has an overwhelming feeling of speed. Here’s a human drama depicting a thrilling battle between life and death, a totally new, outstanding form of entertainment.

The story revolves around Nima Afshar a psychologist, getting underestimated by his family and colleagues constantly,and failing at all his attempts to have a place amongst doctors and society.

Medical Center is a medical drama series which aired on CBS from 1969 to 1976. It was produced by MGM Television.

The medical drama focuses on the lives of doctors and nurses who are members of an elite medical team from the fictional Gwang Hae University Hospital.

No description available for this show.

Onda Kokoro is an oncologist called Dr Onkoro for short by the people around her and teased that she was born for this path. She got married to Takumi, whom she had known since she was a student, and they had a son. Life was going smoothly for her. But three months ago, her husband fell in an accident and remained unconsciousness even though he underwent emergency surgery. Although Kokoro puts on a brave face at work, she still has not been able to accept reality. One day, she meets Kajiyama Kaoru, a competent gastroenterologist who has transferred to work at the hospital. Kaoru understands the need for oncology as a surgeon and gives emotional support with her sunny personality as a colleague. She becomes a dear friend whom Kokoro feels is sudden a ray of light in her personal and professional life…

Shiho works as a neurosurgeon at Nishitokyo General Hospital. She decides to quit her profession after hallucinating during surgery. Her ex-teacher Masayuki Kitabatake is the director at Tokyo University Hospital and he persuades Shiho to work at his hospital in the diagnosis department which consists of all female doctors. Shiho, who is more stubborn in her will to save other patients, sometimes come in conflicts with the other doctors there, but she cooperates with them to reveal a mysterious malady.

In Dragon City, a stoic forensic examiner teams up with a detective, a CSI, and two pivotal women to hunt a serial killer targeting women and removing parts of their bodies. As the clues lead to a chilling discovery, the team races against time to stop the murderer before more lives are claimed.

Childhood nightmares, incomplete memories, and frequent suspicious cases on the way to find the truth about mother's death. Peeling back the onion, the Corpse never lies, a battle between justice and evil is about to unfold...

In Japan's newest medical specialty, general practitioner Tokushige Akira listens closely to his patients' stories, uncovering hidden truths and guiding them toward healing through empathy and conversation.

Eccentric medical examiner Qin Ming, police detective Lin Tao and assistant medical examiner Chen Shiyu team up to find a mysterious killer known only as the 'Scavenger', who specifically targets the wanderers and misfits of the city.

Medical examiner Qin Ming, together with his assistant and a police detective, solves crimes with his expertise.

The story of the Medici family of Florence, their ascent from simple merchants to power brokers sparking an economic and cultural revolution. Along the way, they also accrue a long list of powerful enemies.

we follow forensic scientist Higa Mika as she struggles to step out of Professor Asakawa Toru's shadow and become an independent scientist. For some reason, it seems that she's stuck being his assistant and can't progress any further, when a female junior high school student gets strangled in the jurisdiction of the Nishihara Police Station.

Both brothers and rivals, Kim Su Hyung and Kim Jun Ki are doctors at the same hospital. Young and promising figures in the field, Su Hyung and Jun Ki are dedicated to their profession, though not always as disciplined in other matters. Su Hyung's rash and insensitive personality often brings tears to his longtime girlfriend Min Joo, who is also a doctor. The brothers face crises in both their personal and professional lives when Jun Ki's mistake leads to his friend's wife's passing and Su Hyung discovers a family secret concerning his identity.

No description available for this show.

The story revolves around three gisaeng (Korean geishas) who specialize in sex therapy, with offering sex as the preferred treatment method. Their clients range from a high-profile royalty (a crowned prince who reveals a peculiar sexual dysfunction) to other prominent figures who suffer from impotence and low libido.

No description available for this show.
Their projects are very concrete, sometimes confidential, often breathtaking, always optimistic and will revolutionize our health.

An eclectic group of underfunded yet dedicated doctors and nurses navigates caring for patients — and each other — while keeping it all together at an Oregon hospital.

Follows the personal and professional lives of a group of doctors at Seattle’s Grey Sloan Memorial Hospital.

From murder and espionage to terrorism and stolen submarines, a team of special agents investigates any crime that has any connection to Navy and Marine Corps personnel, regardless of rank or position.

Dr. Gregory House, a drug-addicted, unconventional, misanthropic medical genius, leads a team of diagnosticians at the fictional Princeton–Plainsboro Teaching Hospital in New Jersey.

Shaun Murphy, a young surgeon with autism and savant syndrome, relocates from a quiet country life to join a prestigious hospital's surgical unit. Unable to personally connect with those around him, Shaun uses his extraordinary medical gifts to save lives and challenge the skepticism of his colleagues.

An emotional thrill ride through the day-to-day chaos of the city's most explosive hospital and the courageous team of doctors who hold it together. They will tackle unique new cases inspired by topical events, forging fiery relationships in the pulse-pounding pandemonium of the emergency room.

In the unreal world of Sacred Heart Hospital, John "J.D." Dorian learns the ways of medicine, friendship and life.

The 4077th Mobile Army Surgical Hospital is stuck in the middle of the Korean war. With little help from the circumstances they find themselves in, they are forced to make their own fun. Fond of practical jokes and revenge, the doctors, nurses, administrators, and soldiers often find ways of making wartime life bearable.

A tough, brilliant senior resident guides an idealistic young doctor through his first day, pulling back the curtain on what really happens, both good and bad, in modern-day medicine.

After Wu Suo-wei's girlfriend dumps him, he decides to get revenge by seducing her new boyfriend, Chi Cheng! It started as a game, but falling in love was never part of the plan.

The staff of Pittsburgh's Trauma Medical Center work around the clock to save lives in an overcrowded and underfunded emergency department.

Maomao lived a peaceful life with her apothecary father. Until one day, she's sold as a lowly servant to the emperor's palace. But she wasn't meant for a compliant life among royalty. So when imperial heirs fall ill, she decides to step in and find a cure! This catches the eye of Jinshi, a handsome palace official who promotes her. Now, she's making a name for herself solving medical mysteries!

ER explores the inner workings of an urban teaching hospital and the critical issues faced by the dedicated physicians and staff of its overburdened emergency room.

Perhaps their strikingly different personalities make the relationship between detective Jane Rizzoli and medical examiner Maura Isles so effective. Jane, the only female cop in Boston's homicide division, is tough, relentless and rarely lets her guard down, while the impeccably dressed Maura displays a sometimes icy temperament — she is, after all, more comfortable among the dead than the living. Together, the best friends have forged a quirky and supportive relationship; they drop the protective shield in each other's company, and combine their expertise to solve Boston's most complex cases.

Drama following the lives of a group of midwives working in the poverty-stricken East End of London during the 1950s, based on the best-selling memoirs of Jennifer Worth.

The new medical director breaks the rules to heal the system at America's oldest public hospital. Max Goodwin sets out to tear up the bureaucracy and provide exceptional care, but the doctors and staff are not so sure he can succeed. They've heard this before. Not taking "no" for an answer, Dr. Goodwin's instinctive response to problems large and small is four simple words: "How can I help?" He has to disrupt the status quo and prove he'll stop at nothing to breathe new life into this underfunded and underappreciated hospital, returning it to the glory that put it on the map.

A medical student who becomes a zombie joins a Coroner's Office in order to gain access to the brains she must reluctantly eat so that she can maintain her humanity. But every brain she eats, she also inherits their memories and must now solve their deaths with help from the Medical examiner and a police detective.

Hotshot plastic surgeons Dr. Sean McNamara and Dr. Christian Troy experience full-blown midlife crises as they confront career, family and romance problems.

Chicago Hope is an American medical drama television series, created by David E. Kelley. It ran on CBS from September 18, 1994, to May 4, 2000. The series is set in a fictional private charity hospital in Chicago, Illinois.

Drama series about the staff and patients at Holby City Hospital's emergency department, charting the ups and downs in their personal and professional lives.

Los Angeles County medical examiner Quincy routinely engages in police investigations.

Set 1,300 years after the events of How to Train Your Dragon, dragons are now just a legend to the modern world. When a geological anomaly opens an immense, miles-deep fissure in the Earth’s surface, scientists from all over the world gather at a new research facility to study the mysterious phenomenon. Soon a group of misfit kids, brought to the site by their parents, uncover the truth about dragons and where they’ve been hiding -- a secret they must keep to themselves to protect what they’ve discovered.